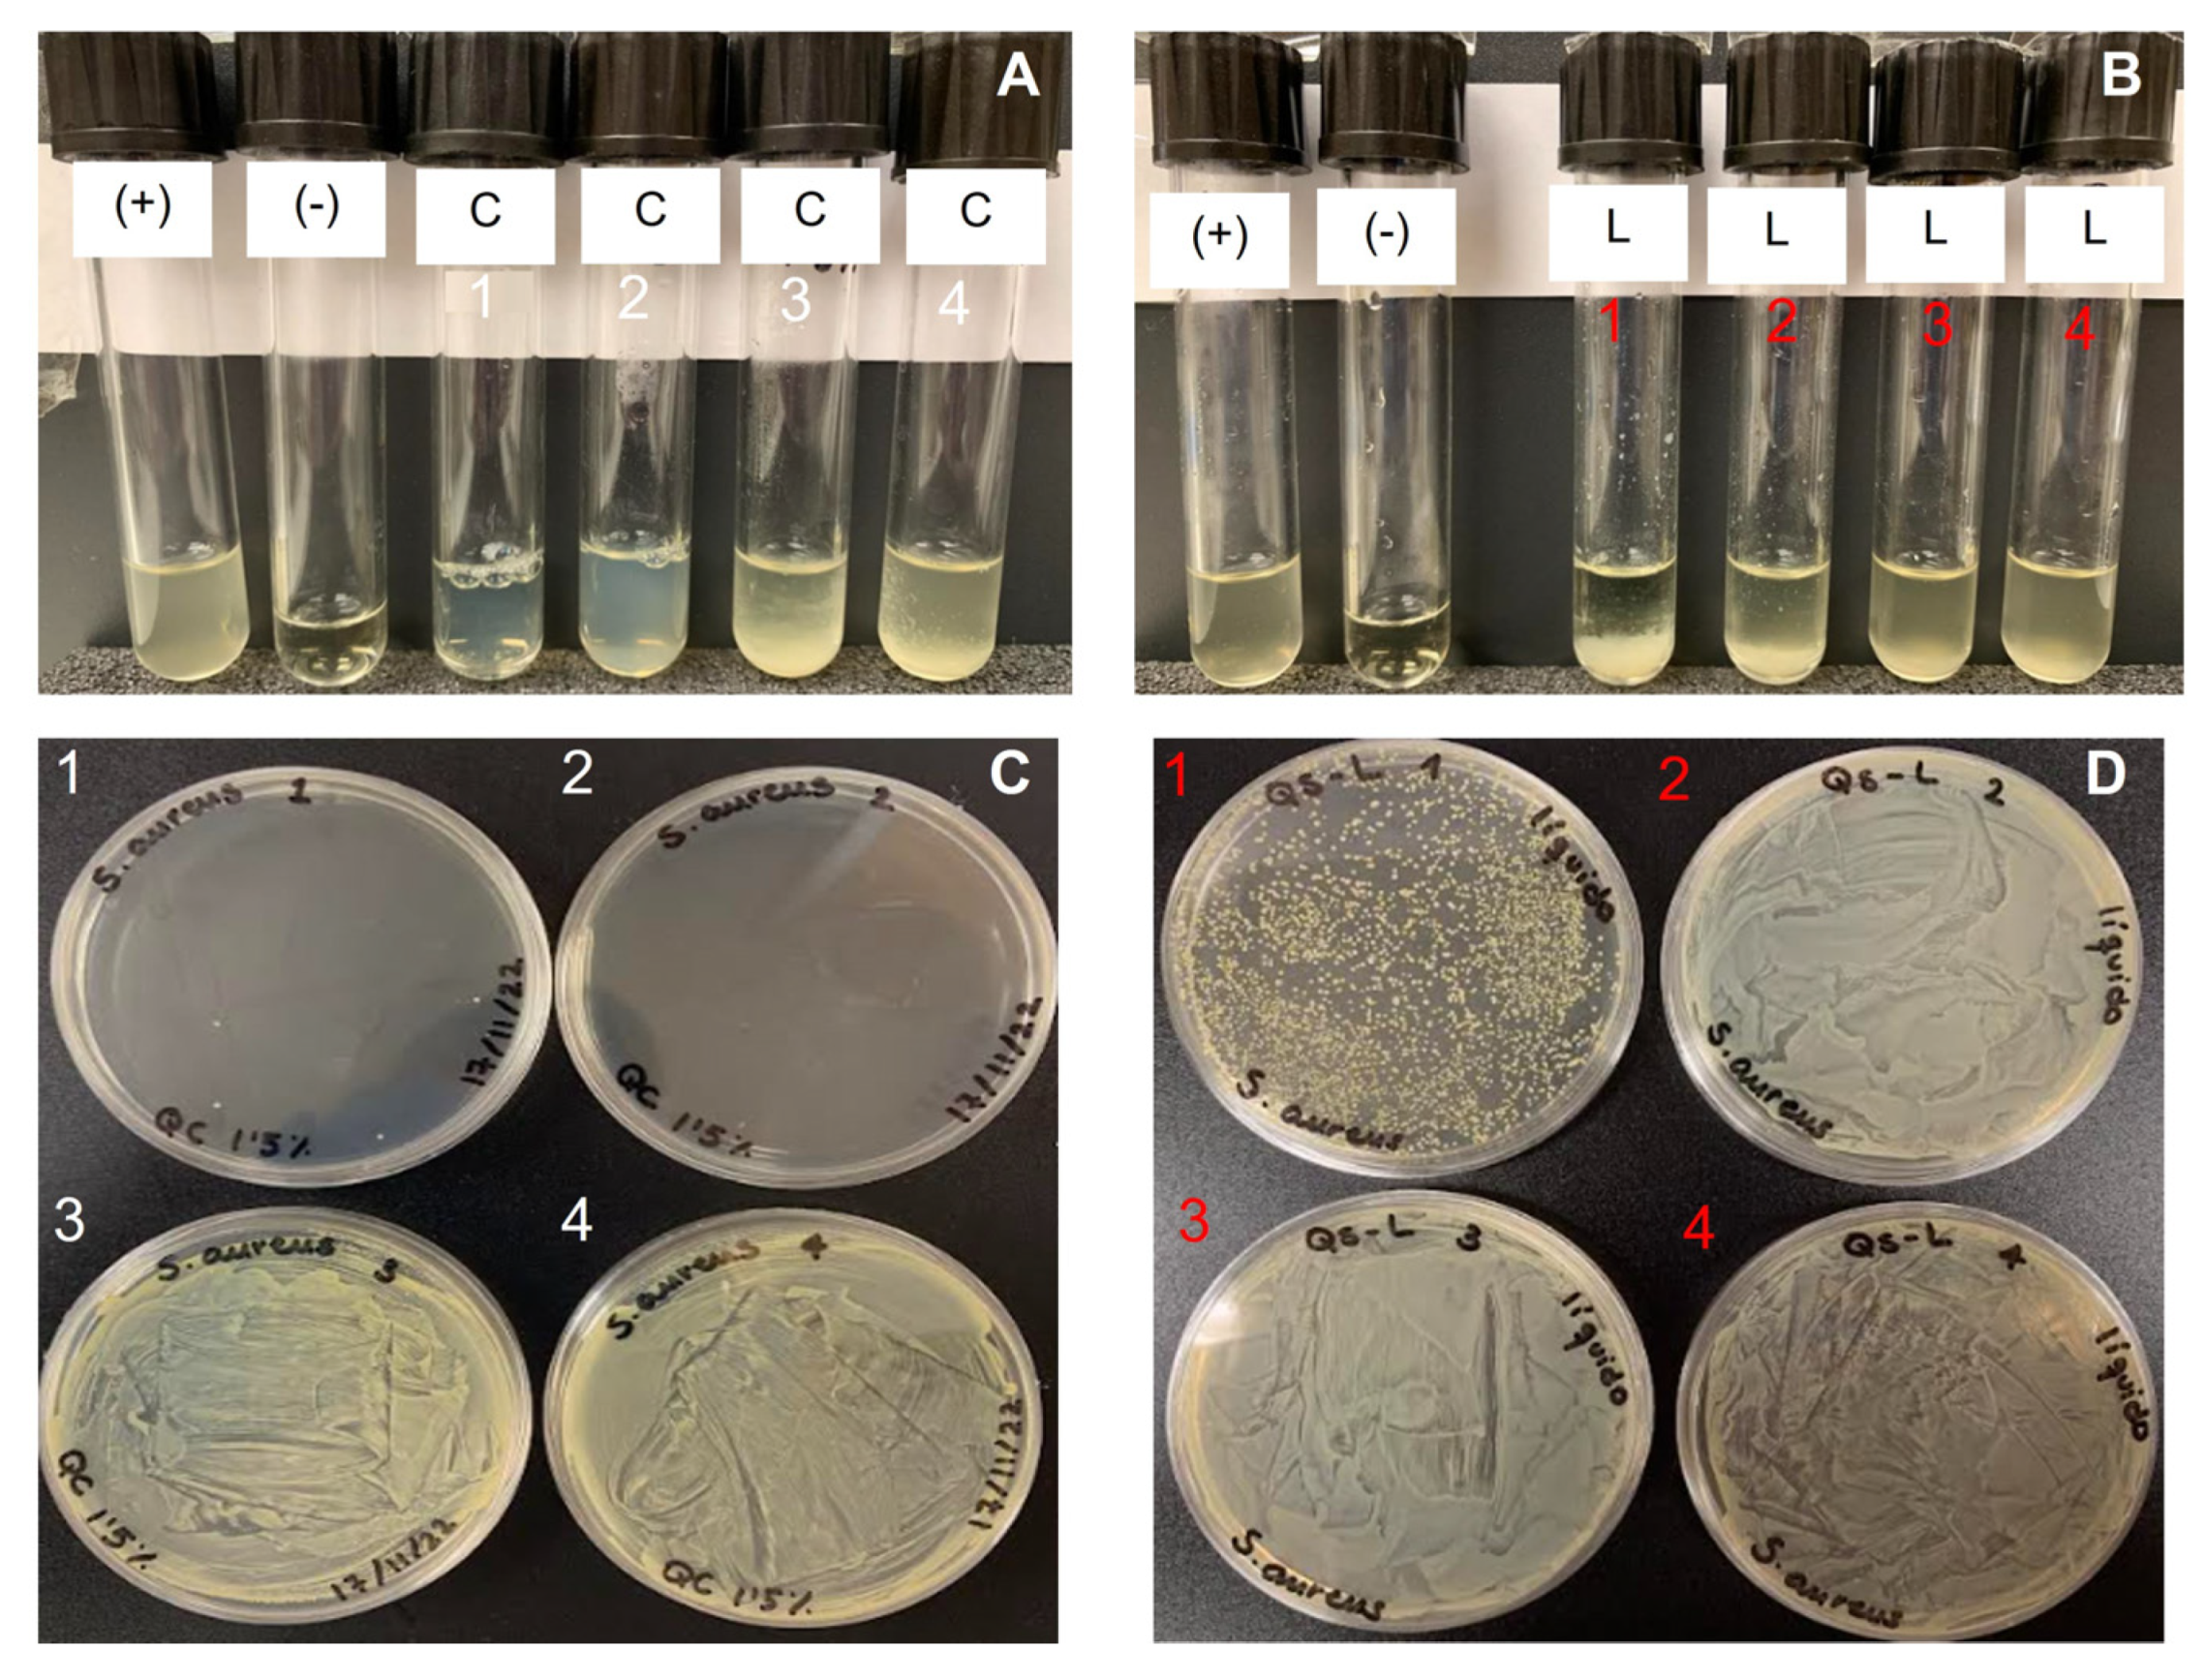
Ijms 23 16125 g010 Ijms 23 16125 g010

Exploring Saduria entomon (Crustacea Isopoda) as a New Source for Chitin and Chitosan Isolation
Abstract
1. Introduction
2. Results
2.1. Chitin and Chitosan Isolation
2.2. Chitin and Chitosan Physicochemical Characterization
2.3. Antioxidant Activity
2.4. Antimicrobial Activity
3. Discussion
4. Materials and Methods
4.1. Preparation of the Material for Further Analysis
4.2. Chitin and Chitosan Extraction Process
4.3. Solubility Test
4.4. Elementary Analysis
4.5. Determination of Acetylation Degree by UV-vis Analysis
4.6. ATR-FTIR Spectra
4.7. Molecular Weight Determination
4.8. Chromatography
4.9. XRD Studies
4.10. Thermal Analysis
4.11. Scanning Electron Microscopy (SEM)
4.12. Antioxidant Activity
4.13. Antimicrobial Activity
5. Conclusions
Author Contributions
Funding
Institutional Review Board Statement
Informed Consent Statement
Data Availability Statement
Acknowledgments
Conflicts of Interest
References
- Benhabiles, M.S.; Salah, R.; Lounici, H.; Drouiche, N.; Goosen, M.F.A.; Mameri, N. Antibacterial activity of chitin, chitosan and its oligomers prepared from shrimp shell waste. Food Hydrocoll. 2012, 29, 48–56. [Google Scholar] [CrossRef]
- Jaworska, M.; Sakurai, K.; Gaudon, P.; Guibal, E. Influence of chitosan characteristic on polymer properties. I: Crystallographic properties. Polym. Int. 2003, 52, 198–205. [Google Scholar] [CrossRef]
- Younes, I.; Rinaudo, M. Chitin and chitosan preparation from marine sources. Structure, properties and applications. Mar. Drugs 2015, 13, 1133–1174. [Google Scholar] [CrossRef] [PubMed]
- Kaya, M.; Baran, T.; Karaarslan, M. A new method for fast chitin extraction from shells of crab, crayfish and shrimp. Nat. Prod. Res. 2015, 29, 1477–1480. [Google Scholar] [CrossRef] [PubMed]
- Islam, S.Z.; Khan, M.; Alam, M.N. Production of chitin and chitosan from shrimp shell wastes. J. Bangladesh Agric. Univ. 2016, 14, 253–259. [Google Scholar] [CrossRef]
- Gadgey, K.K.; Bahekar, A. Studies on extraction methods of chitin from crab shell and investigation of its mechanical properties. Int. J. Mech. Eng. Technol. 2017, 8, 220–231. [Google Scholar]
- Dodane, V.; Vilivalan, V.D. Pharmaceutical applications of chitosan. Pharm. Sci. Technol. Today 1998, 6, 246–253. [Google Scholar] [CrossRef]
- Singh, M.K.; Prajapati, S.K.; Mahor, A.; Rajput, N.; Singh, R. Chitosan: A novel excipient in pharmaceutical formulation: A review. Int. J. Pharm. Sci. 2017, 2, 2266–2277. [Google Scholar]
- Shariatinia, Z. Pharmaceutical applications of chitosan. Adv. Colloid Interface Sci. 2019, 263, 131–194. [Google Scholar] [CrossRef]
- Gurjanova, E.F. Die marinen Isopoden der Arktis. In Fauna Arctica; Romer, F., Schaudinn, F., Brauer, A., Arndt, W., Eds.; Gustav Fischer: Jena, Germany, 1933; pp. 391–470. [Google Scholar]
- Gurjanova, E.F. Pecularities of fauna of the Arctic Ocean and their role in understanding the history of its formation. In The Arctic Ocean and Its Shores in Cainozoic Age; Tolmachev, A.I., Ed.; Gidrometeoizdat: Leningrad, Russia, 1970; pp. 126–161. [Google Scholar]
- Percy, J.A. Distribution of arctic marine isopods of the Mesidotea (=Saduria) complex in relation to depth, temperature, and salinity in Southern Beaufort Sea. Arctic 1983, 36, 341–349. [Google Scholar] [CrossRef]
- Charlesworth, J.K. The Quaternary Era; Wm. Clowes and Sons: London, UK; Beccles, UK, 1957; Volume 2, p. 1700. [Google Scholar]
- Haahtela, I. What do Baltic studies tell us about the isopod Saduria entomon (L.)? Ann. Zool. Fennici. 1990, 27, 269–278. [Google Scholar]
- Mulicki, Z. Ekologia ważniejszych bezkręgowców Bałtyku. In Ecology of the Most Important Invertebrates of the Baltic Sea; Prace MIR: Gdynia, Poland, 1957; pp. 313–380. [Google Scholar]
- Leonardsson, K.; Bengtsson, A.; Linner, J. Size-selective predation by fourhorn sculpin, Myoxocephalus quadricornic (L.) (Pisces) on Mesidotea entomon (L.) (Crustacea, Isopoda). Hydrobiologia 1988, 164, 213–220. [Google Scholar] [CrossRef]
- Leonardsson, K. Growth and reproduction of Mesidotea entomon (Isopoda) in the northern Baltic Sea. Ecography 1986, 9, 240–244. [Google Scholar] [CrossRef]
- Normant, M.; Szaniawska, A. The biochemical composition of Saduria entomon (Mesidotea) entomon (Isopoda) from the Gulf of Gdańsk (southern Baltic). Oceanologia 1996, 38, 113–126. [Google Scholar]
- Janas, U.; Wocial, J.; Szaniawska, A. Seasonal and annual changes in the macrozoobenthic populations of the Gulf of Gdansk with respect to hypoxia and hydrogen sulphide. Oceanologia 2004, 46, 85–102. [Google Scholar]
- Croghan, P.C.; Lockwood, A.P.M. Ionic regulation of the Baltic and freshwater races of the isopod Mesidotea (Saduria) entomon (L.). J. Exp. Biol. 1968, 48, 141–158. [Google Scholar] [CrossRef]
- Sparrevik, E.; Leonardsson, K. Effects of large Saduria entomon (Isopoda) on spatial distribution of their small S. entomon and Monoporeia affinis (Amphipoda) prey. Oecologia 1995, 101, 177–184. [Google Scholar] [CrossRef]
- Dobrzycka, A.; Szaniawska, A. The effect of salinity on osmoregulation in Corophium volutator (Pallas) and Saduria entomon (Linnaeus) from the Gulf of Gdansk. Oceanologia 1995, 37, 111–122. [Google Scholar]
- Dobrzycka-Krahel, A.; Szaniawska, A. The effect of hypoxia and anoxia on osmotic and ionic regulation of Saduria entomon (Linnaeus) from the Gulf of Gdańsk. J. Shellfish Res. 2007, 26, 147–152. [Google Scholar] [CrossRef]
- Dobrzycka-Krahel, A.; Krzak, M.; Szaniawska, A. A laboratory-based comparison of osmoregulatory ability at different water temperatures and salinities in the stenothermic isopod Saduria entomon (Linnaeus, 1758) and the eurythermic amphipod Corophium volutator (Pallas, 1766) from the Baltic Sea. Mar. Freshw. Behav. Physiol. 2014, 47, 29–39. [Google Scholar] [CrossRef]
- Synowiecki, J.; Al-Khateeb, N.A. Production, properties, and some new applications of chitin and its derivatives. Crit. Rev. Food Sci. Nutr. 2003, 43, 145–171. [Google Scholar] [CrossRef] [PubMed]
- Brugnerotto, J.; Lizardi, J.; Goycoolea, F.M.; Argüelles-Monal, W.; Desbrières, J.; Rinaudo, M. An infrared investigation in relation with chitin and chitosan characterization. Polymer 2001, 42, 3569–3580. [Google Scholar] [CrossRef]
- Kassai, M.R. A review of several reported procedures to determine the degree of N-acetylation for chitin and chitosan using infrared spectroscopy. Carbohydr. Polym. 2008, 71, 497–508. [Google Scholar] [CrossRef]
- Muzzarelli, R.A.; Rocchetti, R. Determination of the degree of acetylation of chitosans by first derivative ultraviolet spectrophotometry. Carbohyd. Polym. 1985, 5, 461–472. [Google Scholar] [CrossRef]
- Rinaudo, M.; Milas, M.; Le Dung, P. Characterization of chitosan. Influence of ionic strength and degree of acetylation on chain expansion. Int. J. Biol. Macromol. 1993, 15, 281–285. [Google Scholar] [CrossRef] [PubMed]
- Cárdenas, G.; Cabrera, G.; Taboada, E.; Patricia Miranda, S. Chitin characterization by SEM, FTIR, XRD, and 13C cross polarization/mass angle spinning NMR. J. Appl. Polym. Sci. 2004, 93, 1876–1885. [Google Scholar] [CrossRef]
- Zhang, Y.; Xue, C.; Xue, Y.; Gao, R.; Zhang, X. Determination of the degree of deacetylation of chitin and chitosan by X-ray powder diffraction. Carbohyd. Res. 2005, 340, 1914–1917. [Google Scholar] [CrossRef]
- Tanner, S.F.; Chanzy, H.; Vincendon, M.; Roux, J.C.; Gaill, F. High-resolution solid-state carbon-13 nuclear magnetic resonance study of chitin. Macromolecules 1990, 23, 3576–3583. [Google Scholar] [CrossRef]
- Paulino, A.T.; Simionato, J.I.; Garcia, J.C.; Nozaki, J. Characterization of chitosan and chitin produced from silkworm crysalides. Carbohyd. Polym. 2006, 64, 98–103. [Google Scholar] [CrossRef]
- Aranaz, I.; Alcántara, A.R.; Civera, M.C.; Arias, C.; Elorza, B.; Heras Caballero, A.; Acosta, N. Chitosan: An Overview of Its Properties and Applications. Polymers 2021, 13, 3256. [Google Scholar] [CrossRef]
- Rinaudo, M. Chitin and chitosan: Properties and applications. Prog. Polym. Sci. 2006, 31, 603–632. [Google Scholar] [CrossRef]
- Mengibar, M.; Miralles, B.; Heras, A. Use of soluble chitosans in Maillard reaction products with β-lactoglobulin. Emulsifying and antioxidant properties. LWT 2017, 75, 440–446. [Google Scholar] [CrossRef]
- Kim, K.W.; Thomas, R.L. Antioxidative activity of chitosans with varying molecular weights. Food Chem. 2007, 101, 308–313. [Google Scholar] [CrossRef]
- Jafari, H.; Bernaerts, K.V.; Dodi, G.; Shavandi, A. Chitooligosaccharides for wound healing biomaterials engineering. Mater. Sci. Eng. 2020, 117, 111266. [Google Scholar] [CrossRef]
- Li, X.F.; Feng, X.Q.; Yang, S.; Fu, G.Q.; Wang, T.P.; Su, Z.X. Chitosan kills Escherichia coli through damage to be of cell membrane mechanism. Carbohyd. Polym. 2010, 79, 493–499. [Google Scholar] [CrossRef]
- Seo, H.; Mitsuhashi, K.; Tanibe, H. Antibacterial and Antifungal Fiber Blended by Chitosan; Advances in Chitin and Chitosan; Brine, C.J., Sandford, P.A., Zikakis, J.P., Eds.; Elsevier: London, UK; pp. 34–40.
- Uchida, Y.; Izume, M.; Ohtakara, A. Preparation of chitosan oligomers with purified chitosanase and its application. In Chitin and Chitosan: Sources, Chemistry, Biochemistry, Physical Properties and Applications; Skjåk-Bræk, G., Anthonsen, T., Sandford, P., Eds.; Elsevier: London, UK, 1989; pp. 373–382. [Google Scholar]
- Jeon, Y.J.; Park, P.J.; Kim, S.K. Antimicrobial effect of chitooligosaccharides produced by bioreactor. Carbohyd. Polym. 2001, 44, 71–76. [Google Scholar] [CrossRef]
- Islam, M.; Masum, M.; Khandaker, M.; Haque, M. Antibacterial activity of Crab-Chitosan against Staphylococcus aureus and Escherichia coli. J. Adv. Sci. Res. 2011, 2, 63–66. [Google Scholar]
- Asli, A.; Brouillette, E.; Ster, C.; Ghinet, M.G.; Brzezinski, R.; Lacasse, P.; Jacques, M.; Malouin, F. Antibiofilm and antibacterial effects of specific chitosan molecules on Staphylococcus aureus isolates associated with bovine mastitis. PLoS ONE 2017, 12, e0176988. [Google Scholar] [CrossRef]
- Kumar, M.N.V.R. A review of chitin and chitosan applications. React. Funct. Polym. 2000, 46, 1–27. [Google Scholar] [CrossRef]
- Chitosan Market (By Source: Shrimps, Prawns, Crabs, Others; By Application: Water treatment, Cosmetics, Pharmaceutical and Biomedical, Food and Beverage, Others)-Global Industry Analysis, Size, Share, Growth, Trends, Regional Outlook, and Forecast 2021–2030. Available online: https://www.precedenceresearch.com/chitosan-market (accessed on 3 November 2022).
- Kaya, M.; Baublys, V.; Can, E.; Šatkauskienė, I.; Bitim, B.; Tubelytė, V.; Talat, B. Comparison of physicochemical properties of chitins isolated from an insect (Melolontha melolontha) and a crustacean species (Oniscus asellus). Zoomorphology 2014, 13, 285–293. [Google Scholar] [CrossRef]
- Kaya, M.; Sofi, K.; Sargin, I.; Mujtaba, M. Changes in physicochemical properties of chitin at developmental stages (larvae, pupa and adult) of Vespa crabro (wasp). Carbohydr. Polym. 2016, 145, 64–70. [Google Scholar] [CrossRef] [PubMed]
- Munteanu, I.G.; Apetrei, C. Analytical methods used in determining antioxidant activity: A review. Int. J. Molecular. Sci. 2021, 22, 3380. [Google Scholar] [CrossRef]
- Bagheri, M.; Validi, M.; Gholipour, A.; Makvandi, P.; Sharifi, E. Chitosan nanofiber biocomposites for potential wound healing applications: Antioxidant activity with synergic antibacterial effect. Bioeng. Transl. Med. 2022, 7, e10254. [Google Scholar] [CrossRef] [PubMed]
- Petkovsek, Z.; Elersic, K.; Gubina, M.; Zgur-Bertok, D.; Starcic Erjavec, M. Virulence potential of Escherichia coli isolates from skin and soft tissue infections. J. Clin. Microbiol. 2009, 47, 1811–1817. [Google Scholar] [CrossRef] [PubMed]
- Taylor, T.A.; Unakal, C.G. Staphylococcus Aureus. [Updated 18 July 2022]. In StatPearls [Internet]; StatPearls Publishing: Treasure Island, FL, USA, 2022. Available online: https://www.ncbi.nlm.nih.gov/books/NBK441868/ (accessed on 4 November 2022).
- Fitzmaurice, S.D.; Sivamani, R.K.; Isseroff, R.R. Antioxidant Therapies for Wound Healing: A Clinical Guide to Currently Commercially Available Products. Skin Pharmacol. Physiol. 2011, 24, 113–126. [Google Scholar] [CrossRef]
- Comino-Sanz, I.M.; López-Franco, M.D.; Castro, B.; Pancorbo-Hidalgo, P.L. The Role of Antioxidants on Wound Healing: A Review of the Current Evidence. J. Clin. Med. 2021, 10, 3558. [Google Scholar] [CrossRef] [PubMed]
- Simões, D.; Miguel, S.P.; Ribeiro, M.P.; Coutinho, P.; Mendonça, A.G.; Correia, I.J. Recent advances on antimicrobial wound dressing: A review. Eur. J. Pharm. Biopharm. 2018, 127, 130–141. [Google Scholar] [CrossRef] [PubMed]
- Sánchez, Á.; Mengíbar, M.; Fernández, M.; Alemany, S.; Heras, A.; Acosta, N. Influence of Preparation Methods of Chitooligosaccharides on Their Physicochemical Properties and Their Anti-Inflammatory Effects in Mice and in RAW264.7 Macrophages. Mar. Drugs 2018, 16, 430. [Google Scholar] [CrossRef] [PubMed]
- Wang, Y.W.; Liu, C.C.; Cherng, J.H.; Lin, C.S.; Chang, S.J.; Hong, Z.J.; Liu, C.C.; Chiu, Y.K.; Hsu, S.D.; Chang, A.H. Biological Effects of Chitosan-Based Dressing on Hemostasis Mechanism. Polymers 2019, 11, 1906. [Google Scholar] [CrossRef] [PubMed]
- Hahn, T.; Tafi, E.; Paul, A.; Salvia, R.; Falabella, P.; Zibek, S. Current state of chitin purification and chitosan production from insects. J. Chem. Technol. Biotechnol. 2020, 95, 2775–2795. [Google Scholar] [CrossRef]
- Segal, L.; Creely, J.J.; Martin, A.E.; Conrad, C.M. An empirical method for estimating the degree of crystallinity of native cellulose using the X-ray diffractometer. Text. Res. J. 1959, 29, 786–794. [Google Scholar] [CrossRef]
- Chen, S.K.; Tsai, M.L.; Huang, J.R.; Chen, R.H. In vitro antioxidant activities of low-molecular-weight polysaccharides with various functional groups. J. Agric. Food Chem. 2009, 57, 2699–2704. [Google Scholar] [CrossRef] [PubMed]
- CLSI. Methods for Dilution Antimicrobial Susceptibility Tests for Bacteria That Grow Aerobically; Approved Standard—Ninth Edition; CLSI Document M07-A9; Clinical and Laboratory Standards Institute: Wayne, PA, USA, 2012. [Google Scholar]

| Sample | C, % | H, % | N,% | Ratio C/N |
|---|---|---|---|---|
| Chitin | 47.25 | 6.61 | 6.41 | 7.37 |
| Chitosan | 48.30 | 6.67 | 6.58 | 7.34 |
| Source | Bacteria | Material | CFU Counted | % growth | Growth |
|---|---|---|---|---|---|
| Saduria entomon | E. coli | chitin (CH) | lawn | >99.9% | + |
| chitosan (CHT) | lawn | >99.9% | + | ||
| S. aureus | chitin (CH) | lawn | >99.9% | + | |
| chitosan (CHT) | lawn | >99.9% | + | ||
| Crab | E. coli | chitin (CH) | lawn | >99.9% | + |
| chitosan (CHT) | lawn | >99.9% | + | ||
| S. aureus | chitin (CH) | lawn | >99.9% | + | |
| chitosan (CHT) | lawn | >99.9% | + | ||
| Lobster | E. coli | chitin (CH) | lawn | >99.9% | + |
| chitosan (CHT) | lawn | >99.9% | + | ||
| S. aureus | chitin (CH) | lawn | >99.9% | + | |
| chitosan (CHT) | lawn | >99.9% | + |
| Source | Bacteria | Chitosan Concentration, mg/mL | CFU Counted | Growth, % | Growth |
|---|---|---|---|---|---|
| Saduria entomon | E. coli | 3.34 | >500 | 99.9% | + |
| 1.11 | lawn | >99.9% | + | ||
| 0.37 | lawn | >99.9% | + | ||
| 0.125 | lawn | >99.9% | + | ||
| S. aureus | 3.34 | 0 | 0% | - | |
| 1.11 | 7 | 0.001% | - | ||
| 0.37 | lawn | 99.9% | + | ||
| 0.125 | lawn | >99.9% | + | ||
| Crab | E. coli | 1.5 | lawn | >99.9% | + |
| 0.375 | lawn | >99.9% | + | ||
| 0.1 | lawn | 99.9% | + | ||
| 0.02 | lawn | >99.9% | + | ||
| S. aureus | 1.5 | 4 | 0.0004% | - | |
| 0.375 | 0 | 0% | - | ||
| 0.1 | lawn | >99.9% | + | ||
| 0.02 | lawn | >99.9% | + | ||
| Lobster | E. coli | 3.34 | 0 | 0% | - |
| 1.11 | >500 | 99.9% | + | ||
| 0.37 | lawn | >99.9% | + | ||
| 0.125 | lawn | >99.9% | + | ||
| S. aureus | 3.34 | >500 | 99.9% | + | |
| 1.11 | lawn | >99.9% | + | ||
| 0.37 | lawn | >99.9% | + | ||
| 0.125 | lawn | >99.9% | + |
Publisher’s Note: MDPI stays neutral with regard to jurisdictional claims in published maps and institutional affiliations. |
© 2022 by the authors. Licensee MDPI, Basel, Switzerland. This article is an open access article distributed under the terms and conditions of the Creative Commons Attribution (CC BY) license (https://creativecommons.org/licenses/by/4.0/).
Share and Cite
Rodriguez-Veiga, I.; Acosta, N.; Aranaz, I.; Dobrzycka-Krahel, A. Exploring Saduria entomon (Crustacea Isopoda) as a New Source for Chitin and Chitosan Isolation. Int. J. Mol. Sci. 2022, 23, 16125. https://doi.org/10.3390/ijms232416125
Rodriguez-Veiga I, Acosta N, Aranaz I, Dobrzycka-Krahel A. Exploring Saduria entomon (Crustacea Isopoda) as a New Source for Chitin and Chitosan Isolation. International Journal of Molecular Sciences. 2022; 23(24):16125. https://doi.org/10.3390/ijms232416125
Chicago/Turabian StyleRodriguez-Veiga, Isabel, Niuris Acosta, Inmaculada Aranaz, and Aldona Dobrzycka-Krahel. 2022. "Exploring Saduria entomon (Crustacea Isopoda) as a New Source for Chitin and Chitosan Isolation" International Journal of Molecular Sciences 23, no. 24: 16125. https://doi.org/10.3390/ijms232416125
APA StyleRodriguez-Veiga, I., Acosta, N., Aranaz, I., & Dobrzycka-Krahel, A. (2022). Exploring Saduria entomon (Crustacea Isopoda) as a New Source for Chitin and Chitosan Isolation. International Journal of Molecular Sciences, 23(24), 16125. https://doi.org/10.3390/ijms232416125

